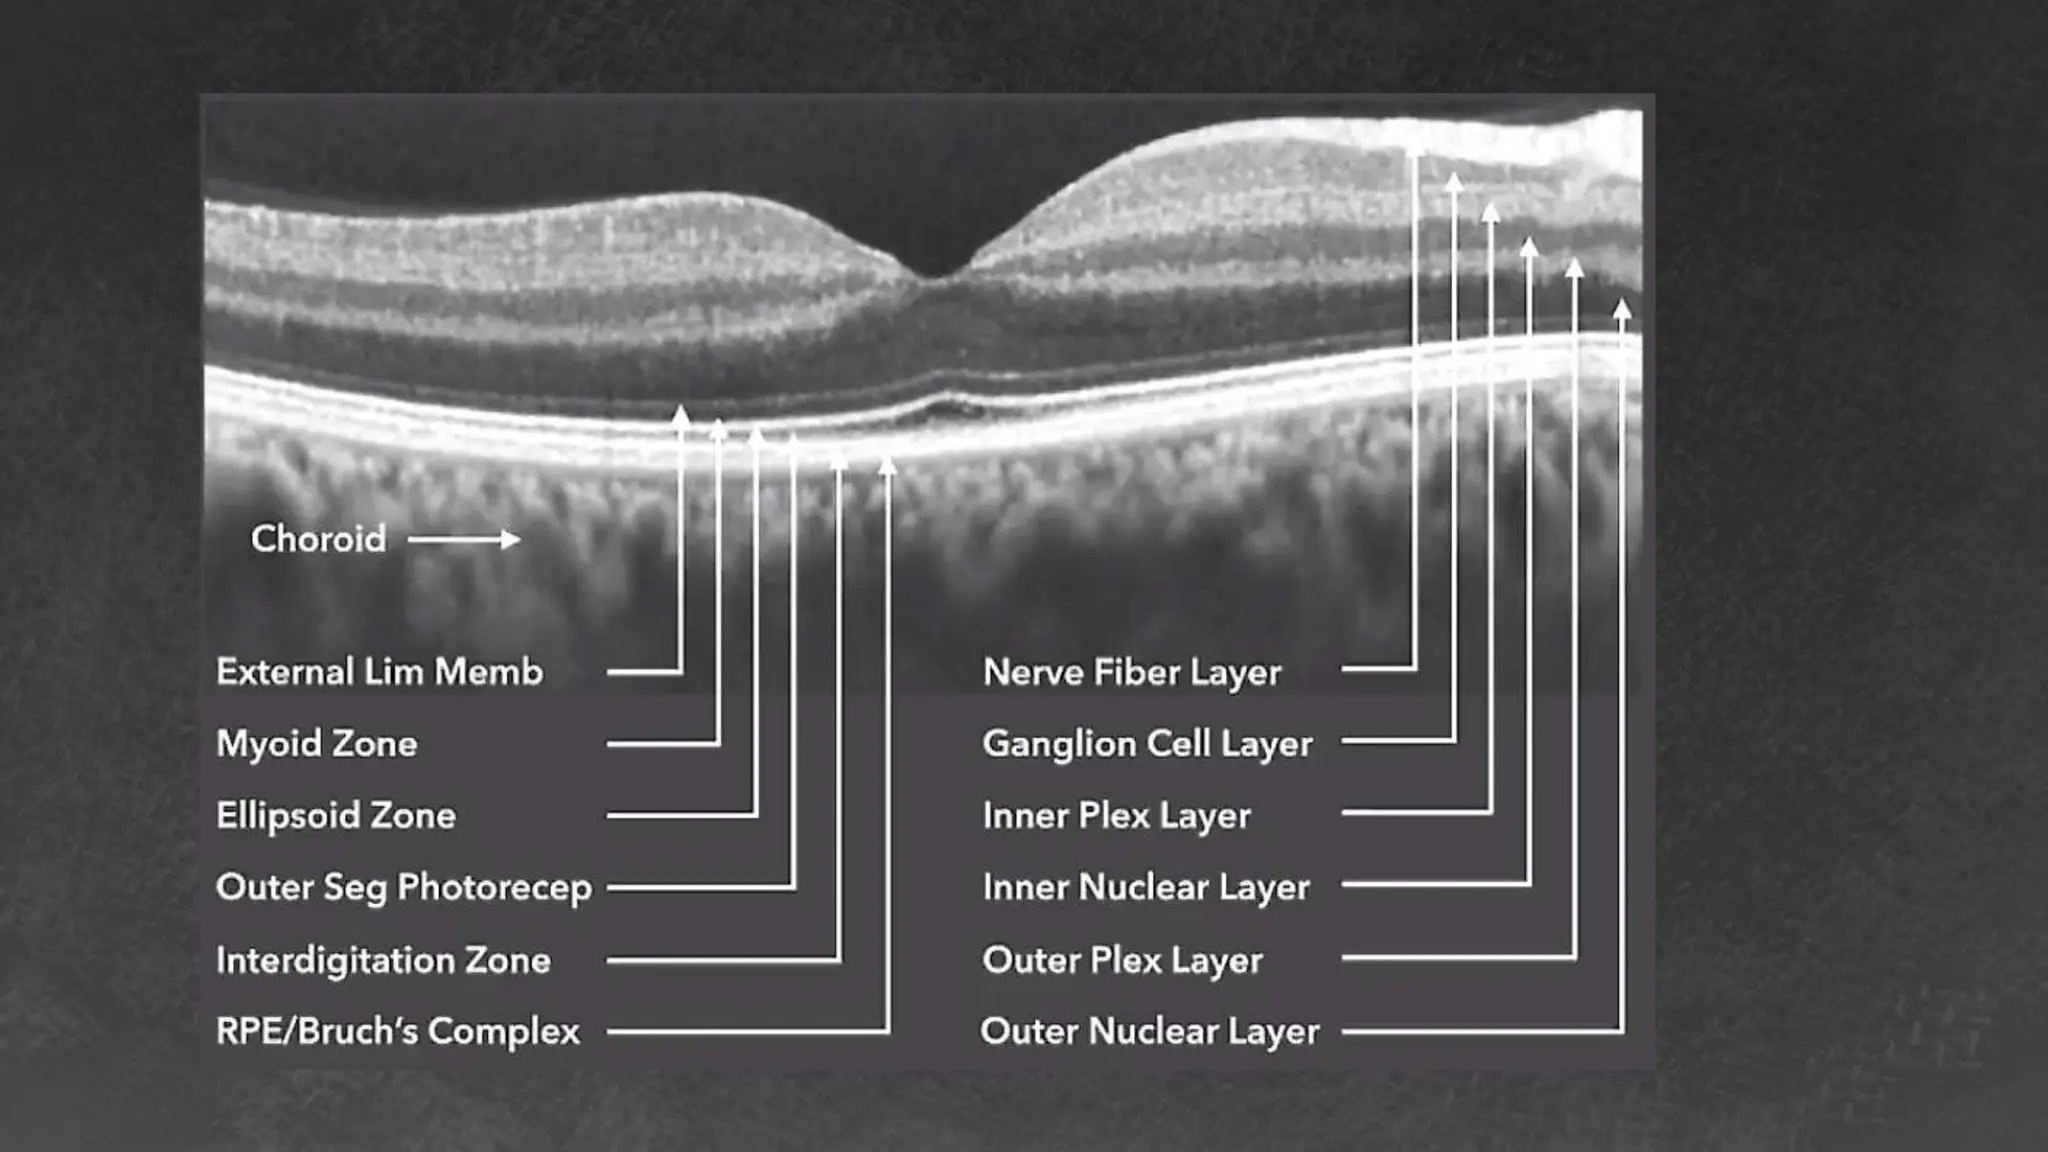
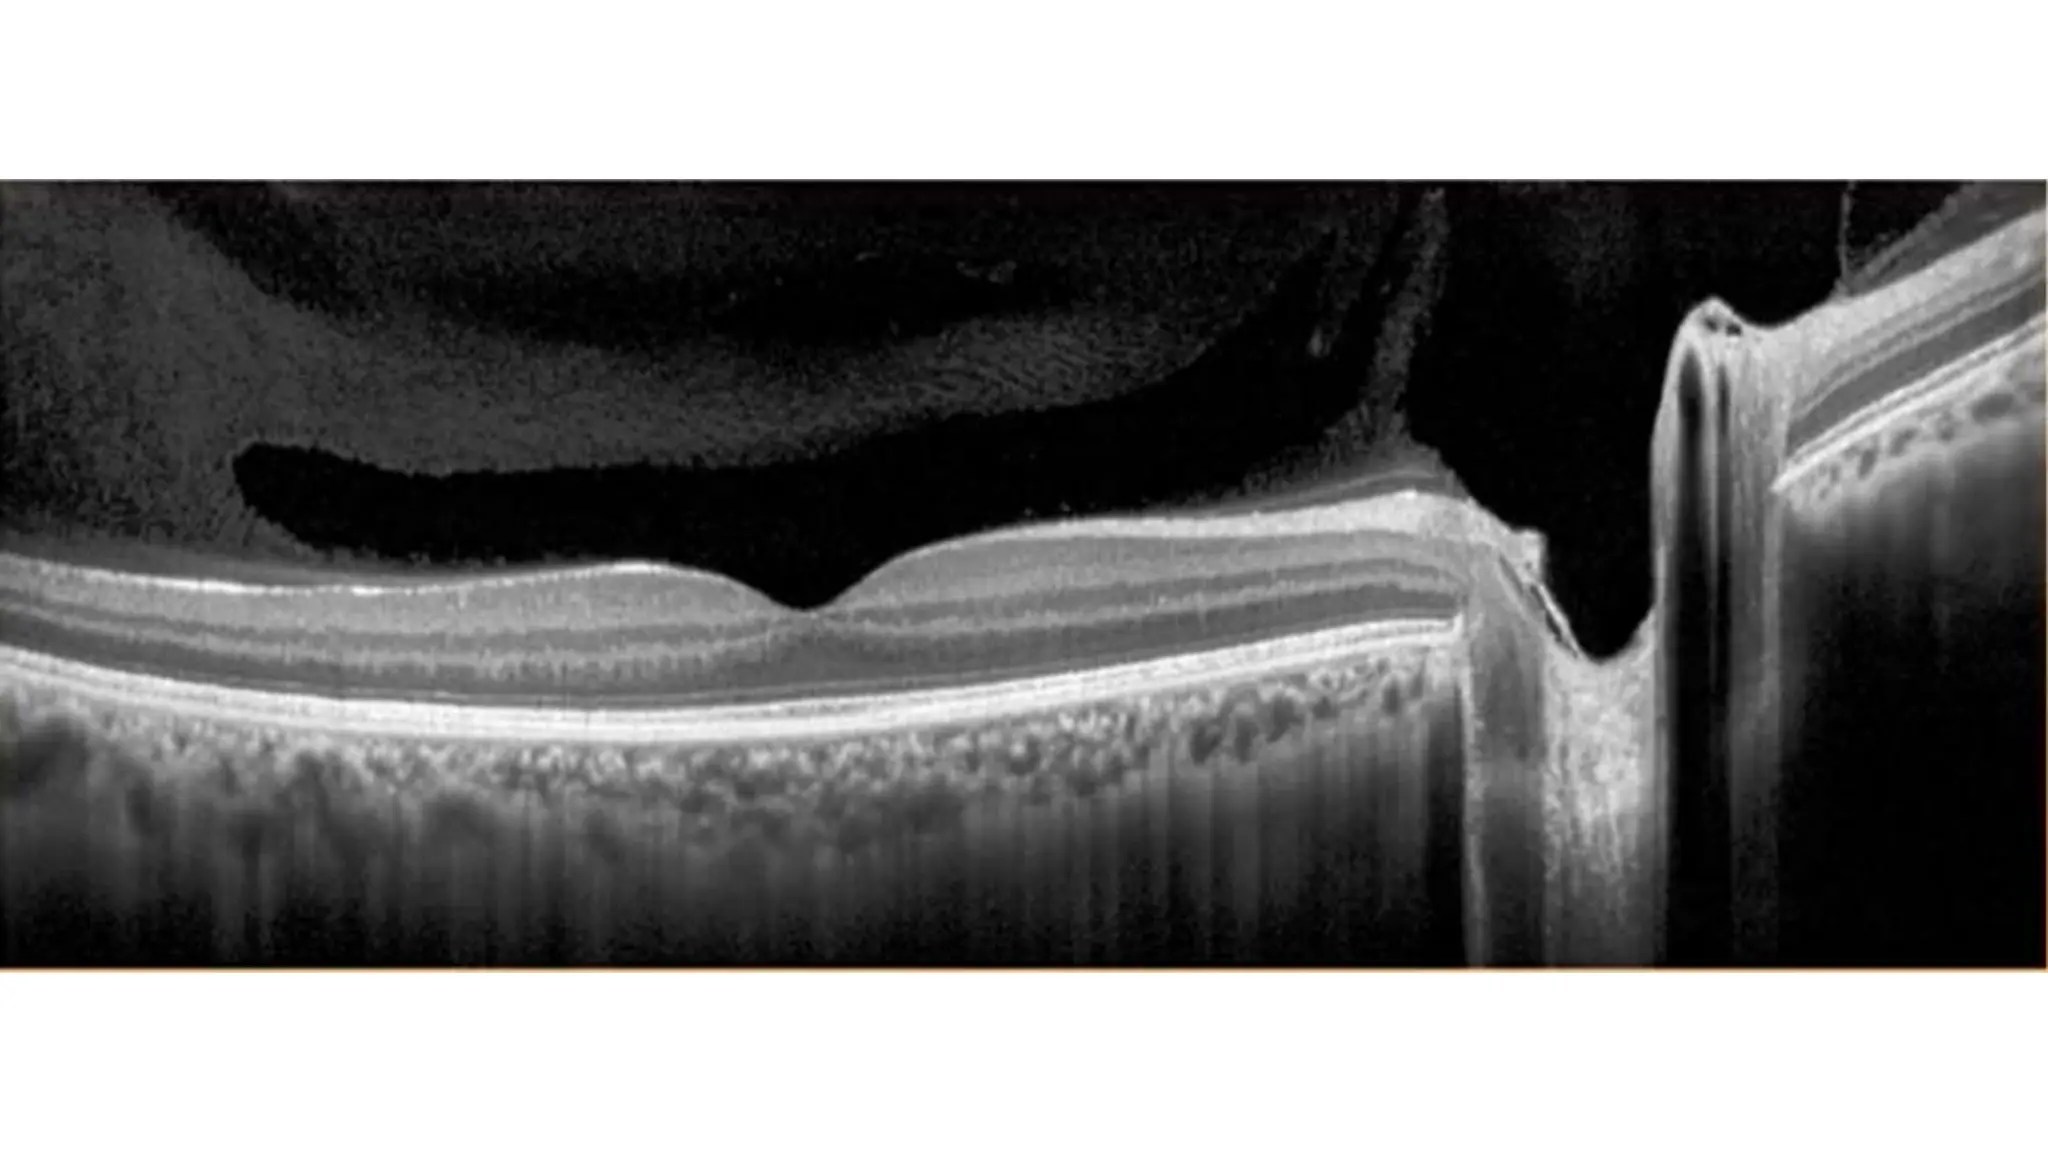

Embed presentation
Download to read offline





















































The document discusses various stages of posterior vitreous detachment (PVD) and associated ophthalmological conditions. It highlights the classification of PVD stages, including no PVD, paramacular PVD, and complete PVD, alongside related factors like traction and retinal issues. Key acronyms and terms relevant to diabetic retinopathy and retinal morphology are also mentioned.